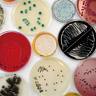

Nieuws
MINDER MELDINGEN VAN VOEDSELINFECTIES IN 2009
In 2009 is een duidelijke daling ten opzichte van voorgaande jaren te zien van het aantal meldingen van voedselinfecties en voedselvergiftigingen. Dit staat vermeld in
DE NVWA SLUIT SNELLE BEDRIJVEN MET VIEZEN KEUKEN
Sinds 2009 hanteert de VWA het motto “Verbeteren of sluiten” voor notoire overtreders. Voor 29 bedrijven heeft dit tot directe sluiting van hun keuken geleid.
KIP IS TOCH OK
Kippenvlees is veilig, ondanks de dikwijlse besmetting met ESBL-producerende bacterien. Vast staat dat deze ESBL vormende bacterie in rauw kippenvlees is gevonden, maar dat dit
MOGEN MINDERJARIGEN SCHOONMAKEN?
Voor veel bedrijven is het nog onduidelijk op welke wijze minderjarige medewerkers om mogen gaan met Reinigings- en Desinfectiemiddelen. Regels hieromtrent zijn vastgelegd in het
VERSRAPPORT 2010
Het Versrapport van 2010 is eind september gepresenteerd. Supermarktketen Jan Linders krijgt van de eigen klanten het hoogste cijfer voor de vers afdelingen, met name
ZELFCONTROLESYSTEEM IN DE SCHIJNWERPERS
Houwers Holtackers is spreker op het VMT-congres “Kwaliteitsmanagement, een lust of een last?” Kom erachter wat deelname aan het zelfcontrolesysteem voor uw organisatie kan betekenen!
EU-ALLERGENENWETGEVING HORECA KRIJGT VORM
Op dit moment geldt de allergenenwetgeving enkel voor voorverpakte voedingsmiddelen. Producten op de markt, versafdeling van de supermarkt of in restaurants zijn niet geetiketteerd. Voor
HET ZELFCONTROLESYSTEEM IN DE PRAKTIJK…
Een van de deelnemers aan het zelfcontrolesysteem is AC Restaurants & Hotels Nederland. Met 19 locaties in Nederland op locaties langs snelwegen een bekende keten
STERFGEVAL DOOR ETEN KROKET
Een 25-jarige Duitse vrouw overleed deze zomer na het eten van een satékroket in een Nederlands cafetaria. Ondanks een pinda-allergie nuttigde de vrouw een satékroket
1 MILJOEN EURO VOOR CERTIFICERING VISKETEN
Minister Gerda Verburg stelt 1 miljoen euro beschikbaar voor het stimuleren van certificering binnen de visketen. Certificering steunt hiermee milieuvriendelijke productiemethoden. De subsidieregeling wordt opengesteld
ICE THIS DAY, WEES WIJS MET IJS!
Op maandag 13 september a.s organiseert het IJscentrum Wageningen in samenwerking met Houwers Holtackers een themadag Voedselveiligheid & Hygiene. Een dag die u als ondernemer/ijsbereider
VEEL OVERTREDINGEN TIJDENS NIJMEEGSE VERDAAGSE
Tijdens de afgelopen Nijmeegse Vierdaagse heeft de VWA bij 188 tijdelijke bedrijfsruimtes waar levensmiddelen werden verkocht gecontroleerd. Het resultaat: 2 boetes en 60 waarschuwingen. De
WET VOEDINGSCLAIMS ETIKETTEN NOG ONVOLDOENDE NAGELEEFD DOOR FABRIKANTEN
Bij 54% van de door de VWA onderzochte producten zijn voedingsclaims op de juiste manier op het etiket vermeld. In 2008 bedroeg dit percentage 43%.

AZO-KLEURSTOFFEN
Azokleurstoffen zijn de meest gebruikte kleurstoffen in levensmiddelen. Circa 60 – 70% van de gebruikte kleurstoffen in levensmiddelen zijn azokleurstoffen. Recent is er een wijziging
GRATIS ADVERTEREN!?
Tegenwoordig zijn er tal van social media te noemen. Computers worden allang niet meer gebruikt om te mailen of informatie te vergaren. Sites als www.hyves.nl,
KWETSBAARHEID BINNEN DE VOEDSELKETEN
Recent is er een start gemaakt met het in kaart brengen van de risico’s en het beheersen van de veiligheid van voedselketens. Hierbij wordt gekeken
SGL EN HOUWERS HOLTACKERS
Op dertien locaties van SGL in Limburg heeft recent een eerste inspectieronde plaatsgevonden. Tijdens deze inspectieronde waren de locaties erg resultaatgericht. En dat bleek; alle
CONSUMENT CHECKT UW KLEUR!
Loopt u ook weleens langs een restaurant of supermarkt en vraagt u zich dan ook weleens af: “Het zal toch wel gecontroleerd worden”? De tijd
ONZE KLANT OVER HET ZELFCONTROLESYSTEEM
“Erg toegankelijk met focus op basale punten” Aan het woord: Dhr. Remco Staals, manager binnen de organisatie Wooninc en deelnemer aan het zelfcontrolesysteem Houwers Holtackers.
SPECIAL EDITION – JUNI 2010
Nieuwsbrief Houwers en Holtackers Nieuwsbrief Houwers Holtackers : Special Edition – juni 2010 In deze nieuwsbrief Verminder het toezicht door de VWA Consument checkt uw
VERMINDER HET TOEZICHT DOOR DE VWA
Als ondernemer zelf controles laten uitvoeren waarmee je de VWA (Voedsel en Waren Autoriteit) en de consument laat zien dat het goed zit met de
ESBL EN KIP
‘Kip kan schadelijk zijn voor de mens.’ Met deze koptekst alarmeerden een tweetal weken geleden de landelijke pers haar lezers. Als gevolg van het toenemend

LISTERIA ACTUEEL
Recent 8 doden door kaas in Oostenrijk en Duitsland De recente aanwezigheid van Listeria monocytogenes in kaas heeft voor een sterftepercentage van 25% gezorgd bij
OPLICHTERS LEGIONELLA
Legionella is een hot item. Iedere ondernemer wil voorkomen dat er een besmetting met legionella kan plaatsvinden en pakt hiervoor alle mogelijkheden aan. De VROM-inspectiedienst
VEILIGHEID OP UW LOCATIE
Wat doet u om de veiligheid van uw medewerkers te garanderen? Binnen uw relatie met Houwers Holtackers staat voedselveiligheid centraal. Met de controle op de
ACTUELE MELDINGEN VOEDSELVEILIGHEID
Wat is momenteel actueel aan meldingen ten aanzien van de voedselveiligheid? Melamine: China hield onlangs een tiendaagse inspectiecampagne bij zuivelbedrijven. Daarbij werd verontreinigde melkpoeder aangetroffen

IJSVAK 2010
Onlangs heeft de jaarlijkse vakbeurs IJSVAK weer plaatsgevonden in de Amsterdam RAI. Vast onderdeel tijdens deze beurs zijn de vakwedstrijden die plaatsvinden. Onze inspecteur Harm

VERBETERRAPPORTEN HH INSPECTIES NU DIGITAAL
Sinds november 2009 is het voor inspectieklanten van Houwers Holtackers mogelijk om verbeterrapporten digitaal in te voeren en te beheren. De inspectieresultaten die Houwers Holtackers
WELKE HYGIËNECODES?
Welke hygiënecodes zijn in Nederland goedgekeurd en waar kan ik dat vinden? Deze vraag krijgen wij regelmatig gesteld. Hygiënecodes spelen een centrale rol bij het

GOED METEN IS ZEKER WETEN’
Dat een goede temperatuurbeheersing een belangrijke basisvoorwaarde is voor veilig voedsel hoeven wij u niet meer te vertellen. In alle stappen van de voedselbereiding -van inkoop grondstoffen

HOUDBAAR TOT HOE LANG?
Het ligt zo voor de hand, maar toch krijgen wij hier regelmatig vragen over de begrippen THT en TGT. Producten voor consumptie zijn niet onbeperkt
HYGIËNE SUPERMARKTEN VERBETERD
Dat blijkt uit een onderzoek van de Voedsel en Waren Autoriteit (VWA) naar de hygiëne in supermarkten. De meeste supermarktketens komen er goed vanaf in

VWA INSPECTIES 2008 IN DE AMBACHTELIJKE SECTOR
Op 26 november 2009 heeft de VWA (Voedsel en Waren Autoriteit) kenbaar gemaakt dat in 2008 minder voedselveiligheidsinspecties bij de ambachtelijke sector, horeca, detailhandel en zorginstellingen zijn uitgevoerd. Het
ACCREDITATIE ISO 17020 VERVOLGD
Afgelopen maand heeft de Raad van Accreditatie een herhalingsbezoek afgelegd bij Houwers Holtackers in het kader van de 17020 accreditatie. Beoordeeld werd of de huidige accreditatietoekenning
KLEURCODERING EN PUNTENTELLING BIJ INSPECTIES
Houwers Holtackers bv voert als geaccrediteerd inspectiebedrijf voor diverse hygiënecodes deskundige, vertrouwde en onafhankelijke inspecties uit. Tijdens de inspectie worden diverse inspectiepunten door de inspecteur beoordeeld, waaruit een
MICROBIOLOGISCHE RICHTWAARDEN IN HYGIËNECODES
In de meeste branche hygiënecodes zijn microbiologische richtwaarden opgenomen waaraan producten die een bepaalde behandeling (meestal verhitting) hebben ondergaan moeten voldoen. De overheid verlangt van ‘hygiënecodehouders’ dat richtwaarden worden opgenomen in de

MEXICAANSE GRIEP EN VOEDSELBEREIDING
Nederland is weer terug van vakantie en ondertussen breidt de Mexicaanse griep én de berichtgeving hierover verder uit. Naast maatregelen die overheid, bedrijven en gezondheidssector nemen, zal de levensmiddelenbranche ook extra
9 JUNI: INTERNATIONALE ACCREDITATIEDAG
International Accreditation Forum (IAF) en de International Laboratory Accreditation Cooperation (ILAC) hebben 9 juni uitgeroepen tot een jaarlijks terugkerende internationale accreditatiedag, om het belang van
DESINFECTIEMIDDELEN
Desinfectiemiddelen zijn al jaren in gebruik voor het elimineren van bacteriën en virussen in de levensmiddelenindustrie. De toelating van deze middelen werd geregeld door het

HYGIËNISCH MACHINE ONTWERP
Bij de aanschaf van nieuwe keukenapparatuur worden vele zaken beloofd over werking en effectiviteit. Maar hoe weet je nu of de apparatuur ook goed te reinigen is

VOEDSELVEILIGHEIDSSTICKERS UPDATE
In de nieuwsbrief van maart 2009 hebben wij al gemeld dat Houwers Holtackers een voedselveiligheidssticker aan klanten uitreikt als zij voldoen aan de inspectiecriteria met
KHN TEGEN OPENBAARMAKING VWA CONTROLERESULTATEN
Sinds kort publiceert de VWA controlegegevens van formulebedrijven op internet. Ketens worden daarbij in drie categorieën verdeeld: groen gelabelde bedrijven die goed presteren, ‘oranje’ bedrijven

RISICOBEOORDELING NOROVIRUS
Recentelijk stond het wereldberoemde driesterrenrestaurant ‘The Fat Duck’ van Heston Blumenthal in de UK in het nieuws: liefst 529 mensen zijn ziek geworden na het
START IJSSEIZOEN
De start van het ijsseizoen kon niet beter voor de meeste professionele ijsbereiders. Het gunstige paasweer heeft voor topomzetten en lege ijsbakken gezorgd. Of ook de
VWA RESULTATEN MICROBIOLOGISCH ONDERZOEK 2007
In januari 2009 is het rapport ‘Microbiologisch onderzoek in levensmiddelen 2007’ gepubliceerd. De Voedsel en Waren Autoriteit is belast met het onderzoeken en bewaken van de veiligheid
CURSUS OF TOETS
Food-medewerkers dienen over voldoende toepasbare hygiënekennis te beschikken bij de uitvoering van hun dagelijkse werkzaamheden. Dat kan op allerlei manieren: interne trainingen, begeleiding op de werkvloer

HOUWERS HOLTACKERS ISO/IEC 17020 GEACCREDITEERD!
Op vrijdag 18 december 2008 heeft Houwers Holtackers B.V. het verlossende telefoontje ontvangen van de Raad voor Accreditatie: de certificering voor de inspectienorm ISO 17020* is

LEVENSMIDDELENAFVAL: GEKOELD OF ONGEKOELD?
De CBL-leden (brancheorganisatie voor supermarkten) hebben in januari 2009 een brief ontvangen van de VWA, hierin wordt aangekondigd dat zij tot 31 mei 2009 de tijd
PUNTENTELLING EN STICKER VOEDSELVEILIGHEID
In de inspectierapporten die Houwers Holtackers opstelt wordt standaard een puntentelling gehanteerd. In het rapport is sprake van een groot aantal beoordelingspunten (meetpunten). Afhankelijk van het belang van

CONSUMENTENBOND FEL TEGEN PRODUCTIE VAST FRITUURVET
Volgens de Consumentenbond bakken cafetaria ondernemers nog steeds op grote schaal in ongezond vast frituurvet dat het schadelijke transvet bevat. Sinds de start in 2004 van